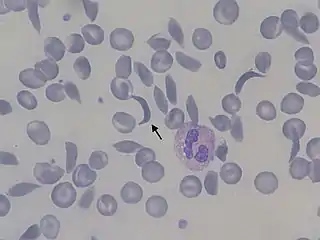

Polipeptídeo
As proteínas são compostos orgânicos formados pela associação de alfa-aminoácidos. São polímeros – ou seja, grandes moléculas – constituídos por monômeros denominados aminoácidos.
O termo polipeptídeo ou peptídeo refere-se a um polímero linear de dois ou mais aminoácidos, estabelecendo ligações peptídicas, que ocorrem entre o grupo terminal carboxila de um aminoácido e o grupo terminal amina de outro. Quando esses grupos ligam-se, ocorre a formação de água (desidratação) em virtude da perda de uma hidroxila do grupo carboxila e de hidrogênio do grupo amina.

Os peptídeos diferem-se uns dos outros pelo número de aminoácidos e pela sequência dessas moléculas. De acordo com o número de aminoácidos que possuem, podemos classificá-los em dipeptídeos, quando são formados por dois aminoácidos; tripeptídeos, quando são formados por três; tetrapeptídeos, quando são formados por quatro aminoácidos, e assim por diante. Quando temos vários aminoácidos ligados, usamos a denominação polipeptídeo. Um peptídeo com mais de setenta aminoácidos é chamado de proteína.
Os polipeptídeos são diferentes dos oligopeptídeos devido ao número de aminoácidos que os constituem. Oligopeptídeo é um peptídeo feito com poucos aminoácidos (oligo = poucos, do grego) e polipeptídeos são peptídeos feitos com muitos aminoácidos (poli = muitos, do grego)
Um polipeptídeo possui estrutura primária (todas as ligações covalentes que ligam os resíduos de aminoácidos em cadeia) e ligações peptídicas entre os aminoácidos:



Um peptídeo pode ainda ser classificado segundo sua natureza acido-básica e isso vai depender do radical “R” de seus aminoácidos. Se a maior parte do polímero tiver “R” que ioniza negativamente, teremos um peptídeo de caráter ácido. Se a maioria tiver na cadeia lateral “R” que ioniza positivamente, teremos um peptídeo de caráter básico.
As proteínas podem assumir diversas configurações moleculares e desta forma contribuir para vários processos celulares. As funções das proteínas são diversas, funções estruturais, no caso de proteínas da membrana celular e citoesqueleto, funções de catálise para as enzimas, reserva energética, regulação osmótica e transporte de substâncias. Para além destas funções, outros papéis desempenhados pelas proteínas são desempenhados no sistema imunitário pelos anticorpos, ou no sistema endócrino através de hormônios de peptídeos ou derivados destes. Por exemplo, o glucágon e a insulina, dois hormônios que se incluem nesta divisão.
Na anemia falciforme, uma doença hereditária, há uma mudança da estrutura primária de uma das cadeias polipeptídica que formam a hemoglobina: o aminoácido ácido glutâmico (GLU) é substituído por um aminoácido valina (VAL) na cadeia beta. A conformação espacial da molécula também é afetada por este "erro" da cadeia primária, isto faz com que as hemácias com esta hemoglobina fiquem com um formato diferente, de foice (por isso falciforme, "em forma de foice"). Estas células modificadas acabam formando agregados de células que obstruem os vasos sanguíneos periféricos causando a hipoxia (falta de oxigênio) e crises de dor intensa.
Referências
MARCONDES, Ayrton. Biologia. 1 ed. São Paulo: Atual Editora, 1998. 576 p.
MCMURRY, John. Química orgânica: Volume 2. 7 ed. São Paulo: CENGAGE Learning, 2012. 614 p.